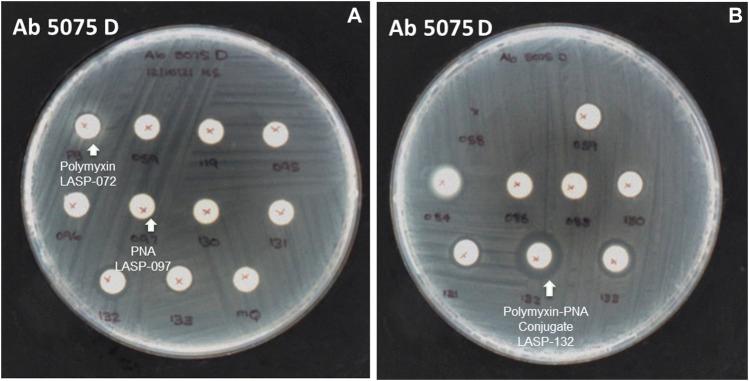
https://cdn.ncbi.nlm.nih.gov/pmc/blobs/25f2/8964499/3f8569e9f7d5/fchem-10-843163-g004.jpg

一种设计与合成抗菌肽-肽核酸缀合物的有效方法。
An Efficient Approach for the Design and Synthesis of Antimicrobial Peptide-Peptide Nucleic Acid Conjugates.
作者信息
Patil Nitin A, Thombare Varsha J, Li Rong, He Xiaoji, Lu Jing, Yu Heidi H, Wickremasinghe Hasini, Pamulapati Kavya, Azad Mohammad A K, Velkov Tony, Roberts Kade D, Li Jian
机构信息
Infection and Immunity Program and Department of Microbiology, Biomedicine Discovery Institute, Monash University, Melbourne, VIC, Australia.
Department of Biochemistry and Pharmacology, The University of Melbourne, Melbourne, VIC, Australia.
出版信息
Front Chem. 2022 Mar 15;10:843163. doi: 10.3389/fchem.2022.843163. eCollection 2022.
Peptide-Peptide Nucleic Acid (PNA) conjugates targeting essential bacterial genes have shown significant potential in developing novel antisense antimicrobials. The majority of efforts in this area are focused on identifying different PNA targets and the selection of peptides to deliver the peptide-PNA conjugates to Gram-negative bacteria. Notably, the selection of a linkage strategy to form peptide-PNA conjugate plays an important role in the effective delivery of PNAs. Recently, a unique Cysteine- 2-Cyanoisonicotinamide (Cys-CINA) click chemistry has been employed for the synthesis of cyclic peptides. Considering the high selectivity of this chemistry, we investigated the efficiency of Cys-CINA conjugation to synthesize novel antimicrobial peptide-PNA conjugates. The PNA targeting acyl carrier protein gene (), when conjugated to the membrane-active antimicrobial peptides (polymyxin), showed improvement in antimicrobial activity against multidrug-resistant Gram-negative . Thus, indicating that the Cys-CINA conjugation is an effective strategy to link the antisense oligonucleotides with antimicrobial peptides. Therefore, the Cys-CINA conjugation opens an exciting prospect for antimicrobial drug development.
靶向细菌必需基因的肽-肽核酸(PNA)缀合物在开发新型反义抗菌药物方面显示出巨大潜力。该领域的大部分工作集中在确定不同的PNA靶点以及选择将肽-PNA缀合物递送至革兰氏阴性菌的肽。值得注意的是,选择形成肽-PNA缀合物的连接策略在PNA的有效递送中起着重要作用。最近,一种独特的半胱氨酸-2-氰基异烟酰胺(Cys-CINA)点击化学已被用于合成环肽。考虑到这种化学的高选择性,我们研究了Cys-CINA缀合合成新型抗菌肽-PNA缀合物的效率。靶向酰基载体蛋白基因的PNA与膜活性抗菌肽(多粘菌素)缀合后,对多重耐药革兰氏阴性菌的抗菌活性有所提高。因此,表明Cys-CINA缀合是将反义寡核苷酸与抗菌肽连接的有效策略。因此,Cys-CINA缀合为抗菌药物开发开辟了令人兴奋的前景。